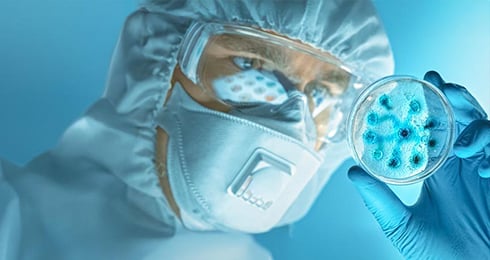
Accelerating-early-cancer-detection-ai-driven-algorithms-for-head-and-neck-cancer-diagnosis

-

 "AI‑first" is not just
"AI‑first" is not just
the wrong answer;
it is the wrong question!Embracing Intelligence in Healthcare & Life Sciences
-
.jpg?width=1680&height=904&name=Banner%20(4).jpg)
 Engineering Tomorrow’s
Engineering Tomorrow’s
Healthcare: Responsibly.
Intelligently.
At Scale.
Experience
This is Where Cyient’s Expertise Becomes Your Competitive Advantage!
We unite deep MedTech domain knowledge, comprehensive silicon-to-software engineering capabilities, and cutting-edge AI platforms to transform visionary concepts into market-leading solutions with sustainable impact. Our integrated approach accelerates next-generation device innovation while modernizing existing infrastructure, enabling organizations to dramatically reduce time-to-market, ensure regulatory excellence, maintain first mover advantage & optimize total lifecycle investments from inception.
CYIENTALK:
Cyient’s healthcare and life sciences platform, hosting podcasts, webinars, and expert-driven content. Where innovation meets insights. Join the Conversation
Comprehensive End-to-End Solutions
Delivering Measurable Impact
Acceleration

Transform Ideas into Market Leaders Faster
- Modular Architecture Excellence: Leverage 100+ proven, reusable technology assets for rapid development
- AI-Powered Automation: Deploy first-in-class and shift-left methodologies to eliminate bottlenecks
- 360° Product Intelligence: Gain comprehensive insights that reduce Total Cost of Ownership
- Streamlined Market Entry: Achieve faster time-to-market with significantly reduced development costs
Ownership

Own Every Phase from Concept to Care
- Integrated LCM Framework: Seamlessly manage R&D, QA/RA, supply chain, and service operations
- AI-Driven Cost Intelligence: Deploy “War-on-Cost” strategies across the entire product lifecycle
- Global Manufacturing Excellence: Maintain robust supply chain and contract manufacturing partnerships
- Optimized Resource Allocation: Lower lifecycle costs while maximizing innovation capacity
Streams

Unlock New Value Streams and Market Opportunities
- Platform X Ecosystem: Enable rapid deployment of connected interoperable solutions
- Complete Interoperability: Ensure seamless integration across healthcare technology stacks
- Strategic Revenue Consulting: Identify and develop breakthrough revenue opportunities
- Rapid Validation Framework: Quickly test and scale innovative use cases with minimal risk

Transform Ideas into Market Leaders Faster
- Modular Architecture Excellence: Leverage 100+ proven, reusable technology assets for rapid development
- AI-Powered Automation: Deploy first-in-class and shift-left methodologies to eliminate bottlenecks
- 360° Product Intelligence: Gain comprehensive insights that reduce Total Cost of Ownership
- Streamlined Market Entry: Achieve faster time-to-market with significantly reduced development costs

Own Every Phase from Concept to Care
- Integrated LCM Framework: Seamlessly manage R&D, QA/RA, supply chain, and service operations
- AI-Driven Cost Intelligence: Deploy “War-on-Cost” strategies across the entire product lifecycle
- Global Manufacturing Excellence: Maintain robust supply chain and contract manufacturing partnerships
- Optimized Resource Allocation: Lower lifecycle costs while maximizing innovation capacity

Unlock New Value Streams and Market Opportunities
- Platform X Ecosystem: Enable rapid deployment of connected interoperable solutions
- Complete Interoperability: Ensure seamless integration across healthcare technology stacks
- Strategic Revenue Consulting: Identify and develop breakthrough revenue opportunities
- Rapid Validation Framework: Quickly test and scale innovative use cases with minimal risk
Supported by Four Services lines
Platform Engineering
Platform engineering supports scalable product development through reusable, cloud-native tools that enable connected services, integrated data, and fast deployment.Data and AI
Leverage data and AI to accelerate product development, drive predictive lifecycle decisions, and enable connected, revenue-generating product ecosystems.Quality and Regulatory Affairs
Accelerate approvals and ensure audit readiness with integrated QMS, AI-powered documentation, and automated compliance checks.Integrated ALM & PLM
Integrated ALM-PLM for traceable DHF and smart manufacturing via digital twins and Industry 4.0 for end-to-end agility and efficiency.Driving MedTech Forward with Our AI Accelerators
Our accelerators help life sciences organizations move faster, stay compliant, and scale with confidence. Powered by GenAI, ML, and RPA, they cut complexity, automate compliance, and safeguard data integrity. From streamlining clinical workflows to boosting engineering productivity, these tools deliver speed, efficiency, and measurable outcomes across the value chain.
MEDICI- Productivity & Lifecyle Automation Platform
Accelerators to boost engineering velocity, streamline compliance, and extend lifecycle value with automation at the core.

DataSphere
AI-powered product data and quality management solution

CyBUILD.AI
GenAI accelerator for faster, error-free code development

CyARC
.jpg)
CyFAST
Automated testing framework to cut verification cycles

PlatformX
Unified digital backbone connecting lifecycle workflows at scale
CliniSphere - Clinical Workflow Automation Platform
Accelerators to simplify imaging, diagnostics, and clinical processes, making them faster, smarter, and more precise.

MediQWorks.AI
Cloud-based accelerator for advanced quantification, diagnostic imaging and analysis.
- Clinical Quantification Workflow → AI-based automated quantification for faster, consistent outcomes.
- Image Rendering → Converts 2D ultrasound into rich 3D visuals for deeper insights.

MediQWorks.AI
Cloud-based accelerator for advanced quantification, diagnostic imaging and analysis.
- Clinical Quantification Workflow → AI-based automated quantification for faster, consistent outcomes.
- Image Rendering → Converts 2D ultrasound into rich 3D visuals for deeper insights.
Co-creating Value with Our Partners

%201.png)



%201.png)
%201.jpg)

.png)


.png)

.png)
.png)
Insights

Why MedTech and Pharmaceutical Companies Must Own Their AI Infrastructure
The case for vertical integration over marketplace dependency

AI‑First Is Not Just The Wrong Answer It's The Wrong Question!
Embracing Intelligence in Healthcare & Life Sciences
Accelerating Early Cancer Detection: AI-Driven Algorithms For Head And Neck Cancer Diagnosis
Traditional cancer diagnostics depend heavily on manual interpretation of pathology images, making early-stage detection prone to human variability.

From Experiments to Engineering: What’s Next for Agentic AI in MedTech
The MedTech industry is clearly entering a new phase. AI has moved beyond hype and early experiments, and starting to show up in real, day-to-day engineering, testing, documentation and clinical workflows.

RSNA 2025 Reflections: Key Trends Shaping the Future of Medical Imaging
RSNA 2025 wasn’t just a conference; it was a marathon. My step tracker proudly logged over 15,000 steps a day, walking hall to hall, booth to booth, absorbing conversations, demos, and emerging technology.

Global Regulatory Monitoring and Intelligence Platform for MDR Compliance
Empowering Medical Device Manufacturers with Cyient & Microsoft’s Agentic AI Solution.

3X Faster Processing. Higher Accuracy. 40% More Business Value. Powered By Our Global Regulatory Monitoring and Intelligence Platform for MDR Compliance.
Built by Cyient and Microsoft to meet global regulatory compliance needs, this platform streamlines workflows and adapts seamlessly to evolving regulations.
Learn more
AI-Led Lifecycle Management: Lessons from Five Industries Shaping the Future of MedTech
Every great product today, whether a car, an aircraft, or a medical device, runs on more code than ever before. In medtech, this shift from hardware-led innovation to software-defined systems has unlocked new possibilities for intelligence, automation, and precision.

From Clinic Visits to Everyday Insight: The Future of Glaucoma Management
For people living with glaucoma, every pressure change matters. Find out how Cyient’s innovation makes real-time monitoring effortless and life-changing.
Learn more
AI-Enabled Assessment of Carotid Stenosis using Dual-scan Ultrasound Views
A Novel Approach using Deep Learning-Based Carotid Artery Quantification in Ischemic Strokes Evaluation using Transverse & Longitudinal Scans
Learn more
Navigating the EU AI Act 2024/1689: A Practical Compliance Playbook for AI-Enabled Medical Devices (AIMD)
Decoding the EU AI Act and its Implications on AI-Enabled Medical Devices
Learn more
Contactless Health Monitoring with RF Technologies
Explore how Cyient’s blog explores contactless health monitoring using RF technologies like radar and Wi-Fi, offering robust, accurate, day/night-capable solutions for non-invasive vital signs measurement.
Learn more
Windows CE End of Life: Transition Challenges for Medical Devices
Learn how Cyient helps medical device makers shift from Windows CE to Linux, ensuring compliance, security, better performance, and future-proofing for healthcare needs.
Learn more
Revolutionizing Prenatal Care: AI-Driven Automated Fetal Biometry for Clinical Diagnosis
Explore how EchoWrks automates fetal biometry with AI-powered 3D visualization, improving accuracy, streamlining workflows, and enhancing prenatal care for mothers and babies.
Learn more
Overview of Drug Approval Process in the United States
Gain insights into the U.S. FDA drug approval process with Cyient’s expertise, covering key regulatory steps, challenges, and safety considerations for market success.
Learn more
3D Visualization and Printing of Cardiac Anatomy for Procedural Planning
Cyient converts 3D DICOM images into interactive models, aiding cardiac procedural planning, surgical precision, and personalized care with 3D printing.
Learn more
Hyperspectral Imaging based on Deep Learning on Google Colab
Cyient’s research uses hyperspectral imaging and deep learning with CNNs to assess fruit ripeness, optimizing agricultural processes and quality analysis.
Learn more
TinyML Optimization Approaches for Deployment on Edge Devices
Cyient optimizes TinyML for edge devices using compression, quantization, and pruning to reduce inference time and enable real-time AI in healthcare, IoT, and wearables.
Learn more
Decoding De Novo Submission Process For Medical Devices in the US
An in-depth overview of the De Novo submission process, outlining the key steps, documentation requirements, considerations, and challenges faced by manufacturers seeking to obtain FDA clearance.
Learn more
AI for Better Screening, Diagnostic, and Management of Digital Health Transformation
From monitoring our daily habits and calorie counting to keeping tabs on our mental health, digital well-being has come a long way, and our dependence on it is only poised to grow with innovations in AI/ML.
Learn more

Overview of Medical Device Regulatory Affairs
Medical device regulatory affairs safeguard public health by controlling the safety and efficacy of products manufactured by medical device companies. Here’s how we will decode it.
Learn more
Overview on Clinical Evaluation for Medical Devices
Understand the critical role of clinical evaluation in ensuring EU MDR compliance, securing CE marking, and maintaining the safety and performance of medical devices in Europe.
Learn more
Embedded Software Testing
The embedded system testing takes time, effort, and money as it combines hardware and software components. Explore a variety of embedded software types, their testing needs, and automation solutions.
Learn more
Decoding ASEAN Medical Device Directive (AMMD) and Accelerating Regulatory Compliance for ASEAN Market
Understand the background, objectives, structure, and potential impact of AMDD on the ASEAN market, the challenges of marketing medical devices, and how Cyient can help medical device companies.
Learn more
Choosing the Right AI-Enabled Robotic Platform for Your Business
Guidelines for selecting the right robot to suit business needs and describes different components of the robot technology stack.
Learn more
Software as Medical Device
Explore Software as a Medical Device and Medical Device Software, regulatory landscape, benefits, challenges faced by manufacturers and how Cyient can help various medical device companies.
Learn more
Hyperspectral Imaging Based on Deep Learning on Google Colab
Discover Cyient's innovative approach to assessing fruit ripeness using a hyperspectral camera and a 2D Convolutional Neural Network (CNN) architecture.
Learn more
Hyperspectral Imaging
Explore the intricacies of hyperspectral imaging, delving into its principles and instrumentation, and diving deep into its applications, majorly focusing on the healthcare industry.
Learn more
Human Factors in Medical Devices
Understand the evolving role of human factors in medical devices and how modern, user-friendly devices—such as smartwatches, handheld scanners, and implants—are also prone to challenges and errors.
Learn more
Three-Dimensional Visualization and Printing of Cardiac Anatomy for Interventional Procedural Planning
Discover the advancements in enhanced visualization techniques for medical imaging, particularly focusing on 3D DICOM images into detailed cardiac anatomy models.
Learn more
TinyML Optimization Approaches for Deployment on Edge Devices
Explore the role of TinyML, a framework for compressing models, in improving the performance of medical Edge devices as the need rises for deep learning models in resource-constrained environments.
Learn more.png?width=774&height=812&name=Master%20final%201%20(1).png)
.jpg)